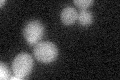
YDL190C
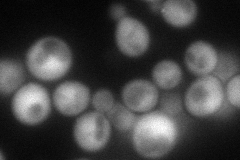
YDL190C
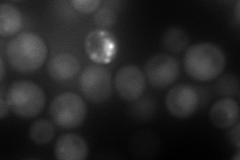
YDL190C
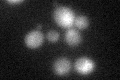
YDL190C
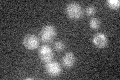
YDL190C

View description
Ubiquitin chain assembly factor (E4) that cooperates with a ubiquitin-activating enzyme (E1), a ubiquitin-conjugating enzyme (E2), and a ubiquitin protein ligase (E3) to conjugate ubiquitin to substrates; also functions as an E3
Localization:
Intensity:
Fold change:
Significance:
-
C’ GFP library in SD
below threshold15.12 -
N' NOP1pr-GFP in SD
cytosol102.482 -
N' TEF2pr-mCherry in SD
punctate,nucleus129.563 -
N' NATIVEpr-GFP in SD

cytosol29.795 -
N' TEF2pr-VC and Cyto-VN in SD

#N/A0 -
C’ GFP library in SD+DTT
cytosol17.091.13No -
C’ GFP library in SD+H2O2

cytosol15.381.01No -
C’ GFP library in Starvation Media
cytosol15.851.04No -
C’ GFP library on the background of Pup2-DaMP

below threshold -
C’ GFP library on the background of CCT mutant

below threshold16.87771.11593No
